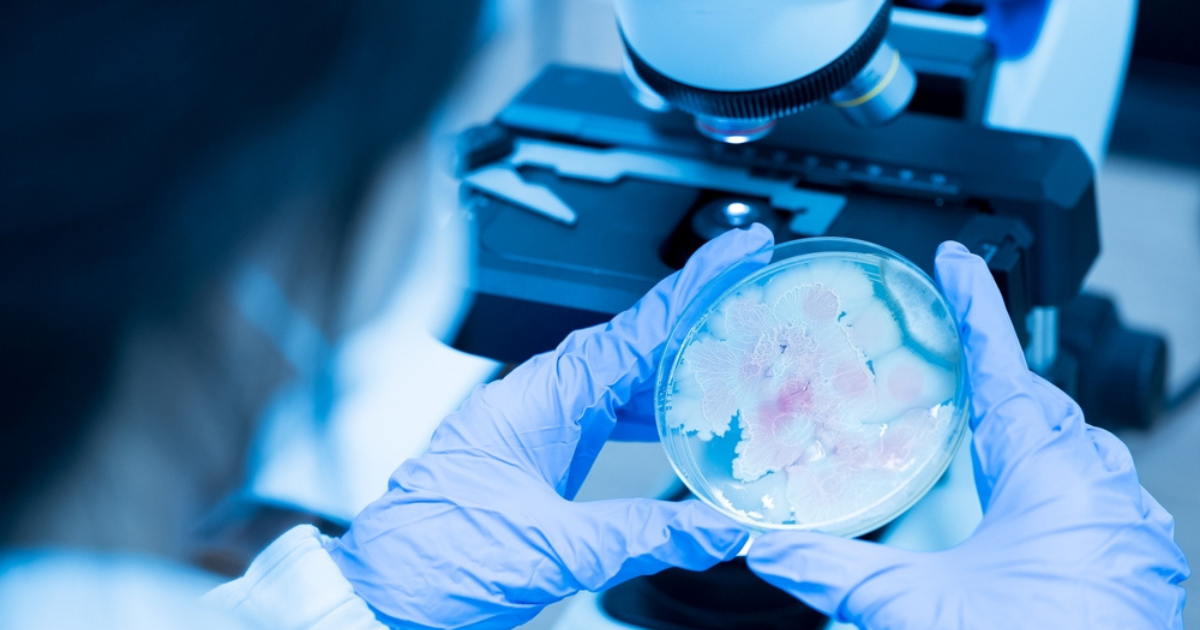

Securing tomorrow’s health: the need for action on AMR and HAIs
Antimicrobial resistance (AMR) and healthcare-associated infections (HAIs) are costing lives and €7 billion per year. A new report from the World Health Organisation found that 1 in 6 bacterial infections involves antibiotic-resistant pathogens – meaning the time to move forward, fast, is now.
Every year, 18 November marks European Antibiotics Awareness Day, which kicks off World AMR Awareness Week (18-24 November). And every year, the crisis gets worse – and the need for action, more urgent than ever.
If, like us, you dedicate your working life to the health or medical sectors, you will know that awareness days for many disease areas are a fixture in our calendars. However, AMR and HAIs are especially deserving of attention given the devastation they can cause.
This is a quiet crisis which threatens to have a truly extraordinary, systemic impact, and yet there is a real risk that – without determined policy action and the adoption of new technologies – we will drift back to the ‘pre-antibiotic era’ when patients died from simple infections and life-saving care could not be delivered safely.
Counting the costs
An estimated 4.3 million patients in EU/EEA hospitals acquire at least one HAI annually, causing serious patient safety challenges, disrupting care delivery, and threatening the sustainability of our health systems.
The economic costs alone are eye-watering – the combined annual cost of AMR and HAIs in Europe exceeds €7 billion – and the burden continues to rise. Taking a wider view, treating complications of resistant infections in 34 OECD and EU/EEA countries, is estimated at about €25 billion every year.
That is funding that could be better deployed elsewhere in our health systems. Spending on AMR and HAIs should be viewed an investment, not a cost. Indeed, every euro spent in this area generates a net return of between €5 and €13 (depending on the intervention).
Scope for cautious optimism?
As startling as the health and economic scenarios can be, the wide range of innovative solutions that can help to tackle this crisis, give us hope. There is no single solution, no ‘silver bullet’, but medical technologies can make a real contribution to preventing and controlling AMR and HAIs, resulting in cost efficiencies.
Medical technologies help protecting patients from infections and resistance every step along the patient pathway, in all settings of care:
- By preventing and containing HAIs through infections prevention technologies ranging from gowns and gloves to antibacterial sutures that reduce the risk of surgical site infections.
- By ensuring the rapid detection and identification of bacterial infections and their susceptibility to antibiotics through rapid diagnostics in the hospital and the community, enabling improved and targeted patient care and outcomes, thus saving costs globally.
- By monitoring and tracking resistance and enabling patient compliance with the appropriate use of antibiotics.
- By tracking, containing, and preventing the spread of pathogens at local, hospital, regional, national, and international levels.
- All of these diverse technologies support healthcare professionals to ensure the targeted prescription of the correct antibiotics, while helping to ensure their effectiveness for future generations.
We therefore have the tools to do much more to address AMR and HAIs, and more innovation is in the pipeline. The challenge is to encourage policies that support the widespread adoption of these technologies across our health systems.
5 steps forward, together
This is a challenge too big for any one partner to tackle alone. MedTech Europe and its members stand ready to partner with policymakers and all stakeholders to advance these urgent priorities, secure public health, and reinforce the foundation for lasting prosperity and resilience in Europe.
To catalyse action in this area, we have set out five key priorities, upon which we elaborate in a new publication, Safeguarding Europe’s Future: A Call to Action on AMR & HAIs.
- Prioritise HAI reduction
- Expand access to rapid diagnostics
- Leverage technology for stewardship
- Invest in innovative technologies and enable new antibiotic development
- Foster integrated approaches
By fully integrating these innovations at every point of care, European health systems can substantially lower infection rates, reduce resistant pathogen transmission, and preserve antibiotic effectiveness for future generations.
We must start now. Because every day should be AMR & HAI awareness day in Europe.














